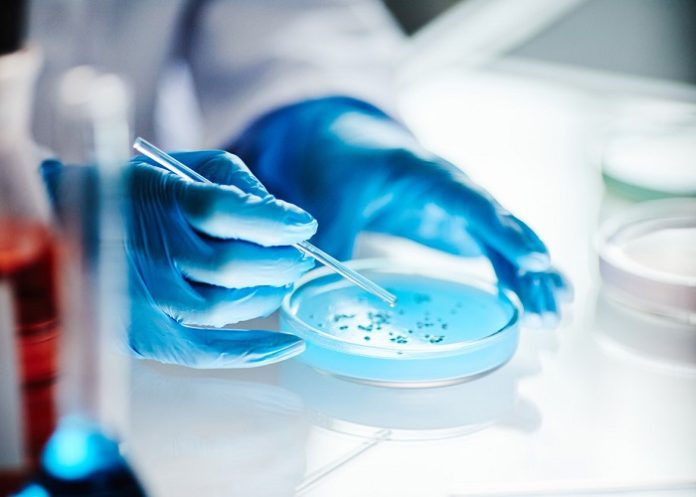

A collaborative study by researchers from several South African institutions and from the United States, has successfully isolated and characterised vaginal bacteria from South African women, contributing more than 20 potential Lactobacillus crispatus strains to develop two multi-strain therapeutic products for the treatment of bacterial vaginosis (BV) in women.
Published in the scientific journal Cell Host & Microbe, the aim of the Vaginal lIve Biotherapeutic RANdomised Trial (VIBRANT) study was to test a new approach to BV treatment using beneficial vaginal bacteria as a live biotherapeutic product.
These products contain multiple strains of Lactobacillus crispatus, a bacterium commonly found in healthy vaginal microbiomes.
BV is one of the most common conditions affecting women, occurring when the healthy bacteria that normally protect the vagina are replaced by other microbes. It’s associated with significant genital inflammation, which can increase the risk of acquiring sexually transmitted infections, including HIV. It is also linked to adverse pregnancy outcomes.
Although antibiotics can treat BV in the short term, the condition frequently returns because the protective bacteria that maintain a healthy vaginal environment often fail to recover after treatment.
“This study shows how microbiome science can move beyond antibiotics to harness beneficial bacteria themselves as medicine – opening the door to a new generation of treatments that restore women’s reproductive health by rebuilding the natural microbial ecosystems that protect it,” said Professor Jo-Ann Passmore from the Division of Medical Virology at the University of Cape Town’s Department of Pathology.
Findings
In this early clinical trial co-led by Dr Caroline Mitchell from Mass Gen Hospital (MGH) in the USA and Dr Disebo Potloane from the Centre for the Aids Programme of Research in South Africa (CAPRISA), the live bacterial products were safe, well tolerated and successfully colonised the vagina in many participants.
In some women, the beneficial bacteria remained detectable several months later, suggesting that this approach could help restore a healthy vaginal microbiome and reduce BV recurrence.
Passmore said that for many years, their research has focused on the vaginal microbiome and genital inflammation in women, particularly in African populations where BV is extremely common and is linked to increased risk of HIV and other reproductive health complications. BV affects around one in three women globally.
“One of the challenges is that current treatments rely almost entirely on antibiotics, which do not address the underlying problem: the loss of protective bacteria. That is why microbiome-based therapies are so exciting. They aim to restore the natural microbial balance of the vagina, rather than simply eliminating bacteria,” she said.
“We were particularly interested in contributing bacterial isolates from women in Cape Town because microbiome therapies should be developed using strains that reflect the diversity of women globally, not only those from Europe or North America.”
Treatment strategies
Passmore said by contributing bacterial isolates from African women whose vaginal microbiomes were naturally dominated by L. crispatus, the researchers hoped to help identify strains that could be used to develop live biotherapeutic products capable of establishing stable colonisation in the vagina.
“Ultimately, the aim is to develop treatments that help women rebuild a protective vaginal microbiome, reducing recurrence of BV and improving reproductive health,” she said.
This research helps in identifying new treatment strategies that work with the body’s natural microbial ecosystem rather than relying solely on antibiotics.
“An important aspect of this project is that it reflects true international collaboration in microbiome science. The live biotherapeutic products tested in the study were developed using L. crispatus strains isolated from women in both the United States and South Africa, thereby reflecting the diversity of vaginal microbiomes across populations.
“Ensuring that African populations are represented in microbiome research is essential if we want to develop effective therapies that benefit women everywhere,” added Passmore.
Study details
VIBRANT: A phase 1 randomised trial of multi-strain vaginal L. crispatus live biotherapeutic products in people with bacterial vaginosis
Disebo Potloane,Laura Symul, Sinaye Ngcapu et al.
Published in Cell Host & Microbe on 18 March 2026
Summary
Bacterial vaginosis (BV) is characterised by high microbial diversity. High recurrence rates following antibiotics may stem from poor recolonisation by protective Lactobacillus species. This phase 1 randomised trial in the United States and South Africa evaluated two vaginally delivered live biotherapeutic products (LBPs) containing multiple Lactobacillus crispatus strains. After metronidazole treatment for BV, participants received either a placebo or three or seven days of active LBPs. LBP strains were detected by metagenomics in 66.1% (47/71) of participants in the active arms in the first five weeks. Among those, nearly half (49%, 23/47) remained colonised at 12 weeks despite the short initial treatment course. Participants were most often colonised by one of three component strains, with no geographic differences in strain colonisation observed. LBPs were safe, acceptable, and well tolerated, with no serious adverse events (AEs) reported. These results provide a foundation for the development of transformational interventions aimed at optimising the vaginal microbiome.
See more from MedicalBrief archives:
UCT team develops device to speed up STI diagnosis
Microbiome therapy reduces recurrent bacterial vaginosis in trial